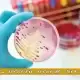
آزمایش AST چیست و چه زمانی تجویز می شود؟ آزمایش AST چیست و چه زمانی تجویز می شود

SGPT در آزمایش خون چیست؟ | میزان نرمال ALT در مردان و زنان + علل بالا بودن
آزمایش AST چیست و چه زمانی تجویز می شود؟
17 اردیبهشت 1401
کراتینین چیست و افزایش آن در خون چه عوارضی دارد؟
19 اردیبهشت 1401
اگر نتیجه آزمایش SGPT شما بالاتر از حد نرمال باشد، طبیعی است که کمی نگران شوید. بسیاری از افراد پس از دریافت نتایج آزمایش خون با همین سؤال مواجه میشوند. SGPT، که به نام آلانین آمینوترانسفراز (ALT) نیز شناخته میشود، آنزیمی مهم است که عمدتاً در سلولهای کبدی وجود دارد و نقش کلیدی در متابولیسم پروتئینها و تبدیل آمینواسیدها دارد. در شرایط طبیعی، مقدار این آنزیم در خون بسیار کم است، اما در صورت آسیب یا التهاب کبد – مانند هپاتیت، مصرف الکل یا عوارض ناشی از داروها – سطح آن افزایش مییابد. آزمایش SGPT بهعنوان یک ابزار تشخیصی اولیه، به شناسایی مشکلات کبدی کمک میکند و میتواند از پیشرفت بیماریها جلوگیری کند.
بر اساس مطالعات انجامشده، شیوع کبد چرب در ایران بین ۳۰ تا ۴۰ درصد گزارش شده است که اغلب با سطوح بالای SGPT همراهی دارد. این آمار نشان میدهد که بیش از یکسوم جمعیت کشور ممکن است با این مشکل مواجه باشند، که عوامل مختلفی نظیر رژیم غذایی نامناسب، کمتحرکی و استرسهای روزمره در آن نقش دارند. سؤالاتی مانند “SGPT در آزمایش خون چیست؟” و “میزان نرمال SGPT چه مقدار است؟” از جمله پرسوجوهای رایج هستند. بهطور کلی، رنج نرمال این آنزیم بین ۷ تا ۵۶ واحد در لیتر (U/L) تعیین شده است، هرچند این مقدار بسته به جنسیت، سن و شرایط بدنی فرد ممکن است متفاوت باشد – بهعنوان مثال، در مردان معمولاً کمی بالاتر از زنان است.
آزمایشگاه پاتوبیولوژی ثمره با بهرهمندی از تجهیزات پیشرفته و کادر متخصص، آماده ارائه خدمات دقیق و قابلاعتماد در این زمینه است. این مقاله با تکیه بر دادههای تجربی و منابع علمی معتبر، بهمنظور پاسخگویی به تمامی سؤالات شما درباره SGPT، از تعریف و شرایط درخواست آن تا علل افزایش یا کاهش آن، درمانها و راهکارهای پیشگیری، نگارش شده است. در صورت مشاهده نتایج غیرعادی یا نیاز به مشاوره، تماس با این آزمایشگاه میتواند گام مؤثری در حفظ سلامت شما باشد. در ادامه، جزئیات بیشتری را بررسی خواهیم کرد.
SGPT (ALT) چیست؟
آلانین آمینوترانسفراز، که به اختصار ALT یا SGPT نامیده میشود، یک آنزیم حیاتی است که بهطور عمده در سلولهای کبدی یافت میشود و نقش کلیدی در متابولیسم پروتئینها ایفا میکند. این آنزیم به بدن کمک میکند تا آمینواسیدها را به انرژی قابل استفاده تبدیل کند، فرآیندی که برای سلامت عمومی کبد و عملکرد صحیح متابولیسم ضروری است. با توجه به اینکه کبد یکی از مهمترین اندامها برای سمزدایی و گوارش در بدن محسوب میشود، اندازهگیری سطح SGPT در آزمایش خون یکی از روشهای اصلی برای ارزیابی سلامت آن است. اگر بهدنبال پاسخی برای سؤال “SGPT در آزمایش خون چیست؟” هستید، باید بدانید که این آنزیم بهعنوان یک نشانگر زیستی عمل میکند که تغییرات آن میتواند زنگ خطری برای مشکلات کبدی باشد.
تفاوت بین SGPT و ALT بیشتر یک موضوع نامگذاری است. SGPT نام قدیمیتر این آنزیم است که در گذشته بیشتر استفاده میشد، در حالی که ALT عنوان استاندارد و مدرن آن محسوب میشود و امروزه در منابع پزشکی معتبر، از جمله سایت extern.ir، بهعنوان اصطلاح پذیرفتهشده شناخته میشود. هر دو نام به یک آنزیم اشاره دارند، اما استفاده از ALT به دلیل انطباق با استانداردهای بینالمللی ترجیح داده میشود. این تغییر نامگذاری به پزشکان کمک میکند تا در تفسیر نتایج آزمایش، از یک زبان مشترک بهره ببرند.
نقش SGPT (ALT) در بدن فراتر از کبد است، هرچند تمرکز اصلی آن روی این اندام است. این آنزیم در مقادیر کمتری در اندامهایی مثل کلیه، قلب و عضلات اسکلتی نیز وجود دارد. با این حال، چون غلظت آن در کبد بالاست، افزایش غیرطبیعی آن در خون معمولاً به آسیب کبدی مرتبط میشود. به همین دلیل، وقتی بحث “میزان نرمال SGPT” یا علل تغییر آن پیش میآید، توجه اول به سلامت کبد معطوف میشود.
چرا باید SGPT در آزمایش خون اندازهگیری شود؟ پاسخ ساده است: این آنزیم در شرایطی که سلولهای کبدی آسیب ببینند – مثلاً به دلیل هپاتیت، کبد چرب یا مصرف الکل – به خون نشت میکند. این نشت باعث افزایش سطح SGPT در آزمایش میشود و به پزشکان کمک میکند تا مشکلات کبدی را در مراحل اولیه تشخیص دهند. در آزمایشگاههای مجهز، مثل آزمایشگاه پاتوبیولوژی ثمره، با بررسی دقیق این مقادیر، میتوان راهنماییهای لازم برای درمان یا پیگیری بیشتر ارائه داد. برای درک بهتر، تصویر زیر ساختار کبد و محل فعالیت SGPT را نشان میدهد که به شما کمک میکند ارتباط آن با سلامت کبد را بهتر تصور کنید.

تفاوت SGPT و SGOT (AST)
یکی از سؤالاتی که اغلب در کنار موضوع “SGPT در آزمایش خون چیست؟” مطرح میشود، تفاوت آن با SGOT است. SGPT (آلانین آمینوترانسفراز یا ALT) و SGOT (آسپارتات آمینوترانسفراز یا AST) هر دو آنزیمهایی هستند که در بدن نقش متابولیک دارند، اما تفاوتهای مهمی بین آنها وجود دارد که درک آن برای تفسیر نتایج آزمایش خون ضروری است. این دو آنزیم اغلب در کنار هم در پانلهای کبدی اندازهگیری میشوند تا تصویر کاملتری از سلامت کبد و سایر اندامها ارائه دهند.
SGPT یا ALT آنزیمی است که بهطور خاص در کبد غالب است و حساسیت بالایی به آسیبهای کبدی نشان میدهد. این ویژگی باعث میشود که افزایش سطح آن در خون، معمولاً به مشکلات کبدی مثل هپاتیت، کبد چرب یا آسیب ناشی از داروها اشاره داشته باشد. در مقابل، SGOT یا AST در کبد، قلب، عضلات اسکلتی و حتی کلیهها یافت میشود و به همین دلیل، افزایش آن میتواند به آسیب در این اندامها نیز مرتبط باشد، نه فقط کبد. این تفاوت در محل فعالیت، SGPT را بهعنوان یک نشانگر اختصاصیتر برای کبد و SGOT را بهعنوان یک شاخص کلیتر برای سلامت بدن مطرح میکند.
برای مقایسه دقیقتر، جدول زیر تفاوتهای کلیدی این دو آنزیم را نشان میدهد:
| پارامتر | SGPT (ALT) | SGOT (AST) |
|---|---|---|
| محل اصلی | کبد | کبد، قلب، عضلات |
| حساسیت به آسیب کبدی | بالا | متوسط |
| رنج نرمال (U/L) | ۷-۵۶ | ۱۰-۴۰ |
رنج نرمال SGOT معمولاً پایینتر از SGPT است و این موضوع به توزیع گستردهتر آن در بدن برمیگردد. در عمل، نسبت SGPT به SGOT (که به آن نسبت د ریت گفته میشود) میتواند سرنخهای مهمی درباره نوع آسیب کبدی ارائه دهد. برای مثال، در هپاتیت حاد، این نسبت اغلب بالاتر از ۱ است، در حالی که در سیروز یا آسیب الکلی کبد، ممکن است کمتر از ۱ باشد.
درک این تفاوتها بهویژه برای بیمارانی که بهدنبال “میزان نرمال SGPT” یا علل تغییر آن هستند، اهمیت دارد. در آزمایشگاه پاتوبیولوژی ثمره، با تحلیل دقیق این دو آنزیم در کنار سایر شاخصها، میتوان تشخیص دقیقتری ارائه داد و راهنماییهای لازم برای پیگیری یا درمان را در اختیار بیماران قرار داد. بنابراین، اگر نتیجه آزمایش شما نشاندهنده تغییر در این مقادیر است، مشورت با متخصص و بررسی جامع نتایج کل پانل کبدی توصیه میشود.
در چه شرایطی آزمایش SGPT درخواست میشود؟
آزمایش SGPT یکی از آزمایشهای کلیدی است که پزشکان برای ارزیابی سلامت کبد و تشخیص مشکلات مرتبط با آن درخواست میدهند. این آزمایش زمانی اهمیت پیدا میکند که علائم یا شرایط خاصی فرد را به خطر ابتلا به بیماریهای کبدی حساس کند. سوال “SGPT در آزمایش خون چیست؟” تنها بخشی از ماجراست؛ دانستن اینکه این آزمایش در چه مواقعی ضروری است، به شما کمک میکند تا اهمیت نتایج آن را بهتر درک کنید.
یکی از شایعترین دلایل درخواست این آزمایش، ظهور علائم مرتبط با اختلالات کبدی است. علائمی مانند خستگی مداوم، زردی پوست یا چشمها (یرقان)، درد در ناحیه بالای شکم (محل کبد)، تهوع، یا کاهش اشتها میتوانند زنگ خطری برای پزشک باشند تا آزمایش SGPT را تجویز کند. این علائم ممکن است نشاندهنده شرایطی مثل هپاتیت، کبد چرب، یا حتی مسمومیت دارویی باشند.
شرایط خاصی نیز وجود دارد که پزشک را به انجام این آزمایش سوق میدهد. افرادی که سابقه مصرف الکل بهصورت مداوم دارند، یا داروهایی مثل استاتینها، NSAIDها، یا داروهای شیمیدرمانی مصرف میکنند، در معرض خطر آسیب کبدی قرار دارند و نیاز به بررسی دورهای SGPT دارند. همچنین، بیماران مبتلا به دیابت، چاقی، یا کسانی که سابقه خانوادگی بیماریهای کبدی دارند، اغلب برای غربالگری روتین از این آزمایش استفاده میکنند. در مواردی مثل نظارت بر درمان هپاتیت یا ارزیابی عوارض پس از جراحی، اندازهگیری مکرر این آنزیم ضروری است.
چکاپهای سالانه نیز میتواند بهعنوان یک اقدام پیشگیرانه، آزمایش SGPT را شامل شود، بهویژه اگر سبک زندگی فرد شامل عوامل پرخطر باشد. در آزمایشگاه پاتوبیولوژی ثمره، ما روزانه با بیمارانی روبرو هستیم که بهمنظور بررسی سلامت عمومی یا پیگیری بیماریهای قبلی، این آزمایش را انجام میدهند. تجربه نشان داده که تشخیص زودهنگام با کمک این آزمایش میتواند از پیشرفت مشکلات کبدی جلوگیری کند. اگر علائم غیرعادی دارید یا بهدنبال “میزان نرمال SGPT” برای مقایسه نتیجهتان هستید، مشورت با پزشک و انجام این آزمایش در زمان مناسب میتواند تصمیمگیری را سادهتر کند.
آمادهسازی برای آزمایش SGPT
برای اطمینان از دقت نتایج آزمایش SGPT، آمادهسازی مناسب پیش از نمونهگیری اهمیت زیادی دارد. این مرحله بهویژه برای افرادی که بهدنبال پاسخ سؤال “SGPT در آزمایش خون چیست؟” هستند و میخواهند نتایج قابلاعتمادی دریافت کنند، حیاتی است. در ادامه، مراحل و نکات لازم برای آمادگی توضیح داده میشود.
ناشتا بودن یا نبودن
بهطور کلی، آزمایش SGPT بهتنهایی نیازی به ناشتا بودن ندارد، مگر اینکه بهعنوان بخشی از یک پانل کامل کبدی (مانند تستهای عملکرد کبد) درخواست شود. در این موارد، پزشکان اغلب توصیه میکنند حداقل ۸ تا ۱۲ ساعت قبل از آزمایش از خوردن غذا خودداری کنید. مصرف آب مجاز است، اما از نوشیدنیهای شیرین یا کافئیندار باید اجتناب شود، زیرا ممکن است بر نتایج تأثیر بگذارد.
اجتناب از الکل و داروها
مصرف الکل حتی در مقادیر کم تا ۲۴ ساعت قبل از آزمایش میتواند سطح SGPT را افزایش دهد و نتایج را نادرست نشان دهد. همچنین، اگر دارویی مثل استاتینها، آنتیبیوتیکها یا مکملها مصرف میکنید، بهتر است با پزشک خود مشورت کنید. در برخی موارد، پزشک ممکن است از شما بخواهد مصرف موقت برخی داروها را متوقف کنید، البته تنها با تأیید او.
زمان مناسب نمونهگیری
بهترین زمان برای انجام آزمایش SGPT معمولاً صبح است، زیرا سطح آنزیمها در طول روز ممکن است کمی نوسان داشته باشد. انتخاب زمان مناسب بهویژه برای بیمارانی که میخواهند “میزان نرمال SGPT” خود را با دقت بررسی کنند، اهمیت دارد. در آزمایشگاه پاتوبیولوژی ثمره، تلاش میشود با هماهنگی زمانبندی مناسب، بهترین شرایط برای نمونهگیری فراهم شود.
نکات تکمیلی
از فعالیت بدنی سنگین یا ورزش شدید قبل از آزمایش خودداری کنید، زیرا این موارد میتوانند بهطور موقت سطح SGPT را بالا ببرند. همچنین، اگر استرس یا بیماری خاصی دارید، آن را با پرسنل آزمایشگاه در میان بگذارید تا نتایج با دقت بیشتری تفسیر شوند. رعایت این نکات ساده میتواند به دریافت نتایج دقیقتر کمک کند و پایهای برای تصمیمگیریهای بعدی درباره سلامت کبد باشد.

روش انجام آزمایش SGPT
آزمایش SGPT یکی از مراحل مهم در ارزیابی سلامت کبد است و دانستن نحوه انجام آن میتواند به شما کمک کند تا با اطمینان بیشتری به نتایج آن اعتماد کنید. اگر بهدنبال پاسخ سؤال “SGPT در آزمایش خون چیست؟” هستید، درک فرآیند این آزمایش بخش مهمی از اطلاعات شما خواهد بود. این آزمایش بهصورت روتین در آزمایشگاهها انجام میشود و روشی ساده اما دقیق دارد.
نمونهگیری خون
فرآیند آزمایش با گرفتن نمونه خون از ورید بازو آغاز میشود. تکنسین آزمایشگاه ابتدا ناحیه موردنظر را با یک ضدعفونیکننده تمیز میکند و سپس با استفاده از سوزنی ظریف، مقدار کمی خون (معمولاً ۵ تا ۱۰ میلیلیتر) را جمعآوری میکند. این کار معمولاً چند دقیقه طول میکشد و در شرایط استریل انجام میشود تا از هرگونه آلودگی جلوگیری شود. ممکن است کمی احساس سوزش یا فشار داشته باشید، اما عارضه جدی بهدنبال ندارد.
زمان دریافت نتایج
پس از نمونهگیری، خون به آزمایشگاه فرستاده میشود تا در دستگاههای پیشرفته آنالیز شود. در آزمایشگاه پاتوبیولوژی ثمره، با بهرهگیری از تجهیزات مدرن، نتایج آزمایش SGPT معمولاً بین ۱ تا ۲ روز کاری آماده میشود. سرعت اعلام نتایج به حجم نمونهها و پیچیدگی پانل کبدی بستگی دارد. اگر نیاز به بررسی فوری باشد، امکان ارائه نتایج در همان روز نیز وجود دارد که با هماهنگی قبلی قابل انجام است.
ایمنی و عوارض
این آزمایش کاملاً بیخطر است و عوارض آن بسیار نادر است. ممکن است پس از نمونهگیری کمی کبودی یا حساسیت در محل تزریق ایجاد شود که با استراحت و کمپرس سرد برطرف میشود. در موارد نادر، اگر سابقه حساسیت به سوزن یا خونریزی دارید، بهتر است قبل از آزمایش به پرسنل اطلاع دهید. هدف اصلی، اطمینان از این است که نتایج دقیق و قابلاعتمادی برای ارزیابی “میزان نرمال SGPT” و تشخیص مشکلات احتمالی کبد به دست آید.
این فرآیند ساده اما مؤثر، به پزشکان کمک میکند تا با تحلیل سطح SGPT، سلامت کبد را ارزیابی کنند و در صورت نیاز، اقدامات بعدی را پیشنهاد دهند. اگر قصد دارید این آزمایش را انجام دهید، هماهنگی با آزمایشگاه پاتوبیولوژی ثمره میتواند تجربهای مطمئن و حرفهای برایتان فراهم کند.
میزان نرمال SGPT در آزمایش خون
یکی از سؤالاتی که اغلب پس از انجام آزمایش SGPT مطرح میشود، این است که “میزان نرمال SGPT” چه مقدار است و چگونه میتوان آن را تفسیر کرد. این آنزیم، که بهعنوان یکی از شاخصهای اصلی سلامت کبد شناخته میشود، رنج مشخصی دارد که بسته به جنسیت، سن و شرایط بدنی فرد ممکن است کمی متفاوت باشد. درک این رنج به شما کمک میکند تا نتایج آزمایش خود را بهتر ارزیابی کنید و در صورت نیاز، اقدامات لازم را انجام دهید.
رنج عمومی و تفاوتهای جنسیتی
بهطور کلی، میزان نرمال SGPT در بزرگسالان سالم بین ۷ تا ۵۶ واحد در لیتر (U/L) تعیین شده است. با این حال، این مقدار بسته به جنسیت میتواند متفاوت باشد. در مردان، به دلیل داشتن توده عضلانی بیشتر، رنج نرمال معمولاً بین ۱۰ تا ۴۰ U/L است، در حالی که در زنان این رنج اغلب بین ۷ تا ۳۵ U/L گزارش میشود. این تفاوت به دلیل فعالیت متابولیک بالاتر در مردان و تأثیر هورمونها در زنان است. برای کودکان، رنج نرمال کمی متفاوت است و معمولاً بین ۵ تا ۴۵ U/L متغیر است، که با افزایش سن بهتدریج به مقادیر بزرگسالان نزدیک میشود.
عوامل تأثیرگذار
علاوه بر جنسیت، عوامل دیگری مانند سن، نژاد، و شاخص توده بدنی (BMI) میتوانند بر میزان نرمال SGPT اثر بگذارند. بهعنوان مثال، افراد مسن ممکن است به دلیل کاهش فعالیت کبد، مقادیر کمی پایینتری داشته باشند. همچنین، ورزشکاران یا افرادی با عضلات قوی ممکن است بهطور طبیعی سطح بالاتری داشته باشند که در محدوده سالم قرار دارد. تغییرات روزانه نیز طبیعی است و ممکن است تا ۱۰ تا ۳۰ درصد نوسان داشته باشد، بهویژه پس از فعالیت بدنی یا غذا خوردن.
جدول رنج نرمال
برای سهولت در مقایسه، جدول زیر رنجهای نرمال SGPT را بر اساس گروههای مختلف نشان میدهد:
| گروه سنی/جنسیت | میزان نرمال SGPT (U/L) |
|---|---|
| مردان بالغ | ۱۰-۴۰ |
| زنان بالغ | ۷-۳۵ |
| کودکان (زیر ۱۲ سال) | ۵-۴۵ |
اهمیت تفسیر دقیق
با وجود این رنجها، تفسیر نتایج باید توسط پزشک و با در نظر گرفتن شرایط خاص هر فرد انجام شود. اگر بهدنبال “میزان نرمال SGPT” برای مقایسه نتیجه آزمایش خود هستید، توجه داشته باشید که مقادیر کمی خارج از این رنج ممکن است همیشه نشاندهنده مشکل نباشد. در آزمایشگاه پاتوبیولوژی ثمره، با تحلیل دقیق و مشاوره حرفهای، تلاش میشود تا نتایج بهطور کامل برای شما توضیح داده شود و در صورت نیاز، راهنماییهای لازم برای پیگیری ارائه گردد.
علل بالا بودن SGPT در آزمایش خون
افزایش سطح SGPT در آزمایش خون میتواند نشانهای از مشکلاتی در کبد یا سایر اندامها باشد و دانستن دلایل آن برای افرادی که بهدنبال پاسخ “SGPT در آزمایش خون چیست؟” هستند، بسیار مهم است. این آنزیم وقتی از سلولهای کبدی به خون نشت میکند، معمولاً به آسیب یا التهاب مرتبط است، و شدت افزایش آن میتواند سرنخهایی درباره علت اصلی ارائه دهد.
سطوح مختلف افزایش SGPT
- خفیف (تا ۱۰۰ U/L): افزایش جزئی SGPT ممکن است به عواملی مثل چاقی، مصرف داروهای خاصی مانند استاتینها، یا ورزش شدید مرتبط باشد. این سطح اغلب موقتی است و با تغییر سبک زندگی قابل مدیریت است.
- متوسط (۱۰۰ تا ۳۰۰ U/L): این رنج معمولاً هشداری جدیتر است و میتواند به بیماریهایی مثل هپاتیت ویروسی (A، B یا C)، مصرف بیشازحد الکل، یا کبد چرب غیرالکلی اشاره کند. این شرایط نیاز به بررسی بیشتر دارد.
- شدید (بیش از ۳۰۰ U/L): مقادیر بسیار بالا اغلب با مشکلات حاد مثل سیروز کبدی، مسمومیت دارویی (مثل استامینوفن بیشازحد)، یا شوک همراه است و نیاز به مداخله فوری پزشکی دارد.
علائم و عوامل مرتبط
افزایش SGPT معمولاً با علائمی مثل زردی پوست و چشمها (یرقان)، خستگی مداوم، یا درد در ناحیه کبد همراه است. عواملی که میتوانند این وضعیت را ایجاد کنند شامل عفونتهای ویروسی (مثل هپاتیت)، مصرف طولانیمدت داروهای ضدالتهابی غیراستروئیدی (NSAIDها)، استاتینها، و حتی بیماریهای خودایمنی کبد میشود. بر اساس مشاهدات، در ایران، کبد چرب به دلیل رژیمهای غذایی پرچرب و کمتحرکی یکی از شایعترین علل است.
بررسی و اقدام
اگر نتیجه آزمایش شما نشاندهنده افزایش “میزان نرمال SGPT” باشد، پزشک ممکن است آزمایشهای تکمیلی مثل سونوگرافی کبد یا تستهای هپاتیت را توصیه کند. در آزمایشگاه پاتوبیولوژی ثمره، با تحلیل دقیق این نتایج و ارائه گزارشهای جامع، تلاش میشود تا بیماران بتوانند با آگاهی کامل به سراغ درمان بروند. تشخیص زودهنگام و شناسایی علت اصلی میتواند از عوارض جدیتر جلوگیری کند.
علل پایین بودن SGPT و اهمیت آن
کاهش سطح SGPT در آزمایش خون معمولاً کمتر مورد توجه قرار میگیرد، اما درک دلایل آن برای افرادی که بهدنبال پاسخ “SGPT در آزمایش خون چیست؟” هستند، میتواند اطلاعات مفیدی در اختیارداشتن دهد. اگرچه پایین بودن این آنزیم بهطور کلی نگرانکننده نیست، اما در برخی موارد خاص ممکن است به شرایطی اشاره کند که ارزش بررسی دارد.
دلایل کاهش SGPT
پایین بودن SGPT معمولاً نادر است و اغلب به کمبود ویتامین B6 (پیریدوکسین) مرتبط میشود، زیرا این ویتامین برای فعالیت آنزیمها ضروری است. در زنان باردار، به دلیل تغییرات هورمونی و متابولیک، ممکن است سطح SGPT بهطور طبیعی کمی کاهش یابد که معمولاً طبیعی تلقی میشود. همچنین، در شرایطی مثل سوءتغذیه شدید یا بیماریهای مزمن که فعالیت کبد کاهش مییابد، این مقدار ممکن است پایینتر از حد نرمال باشد. با این حال، این موارد به ندرت بهعنوان مشکل اصلی مطرح میشوند.
اهمیت و تفسیر
برخلاف افزایش SGPT که اغلب با آسیب کبدی مرتبط است، کاهش آن بهندرت نشانه بیماری جدی است و معمولاً نیاز به مداخله فوری ندارد. با این حال، اگر “میزان نرمال SGPT” شما بهطور مداوم پایینتر از رنج ۷ U/L باشد، مشورت با پزشک میتواند کمک کند تا مطمئن شوید این وضعیت به دلیل کمبود مواد مغذی یا مشکل دیگری نیست. در بسیاری از موارد، این کاهش بدون علامت است و با بهبود رژیم غذایی یا مکملها برطرف میشود.
توصیهها
در آزمایشگاه پاتوبیولوژی ثمره، با بررسی نتایج کل پانل کبدی و تاریخچه پزشکی بیمار، تلاش میشود تا کاهش غیرطبیعی SGPT بهطور دقیق ارزیابی شود. اگر این موضوع برایتان نگرانکننده است، انجام آزمایشهای تکمیلی مثل بررسی سطح ویتامینها یا تستهای عملکرد کبد میتواند تصویر کاملتری ارائه دهد. در اکثر موارد، پایین بودن SGPT بهتنهایی دلیلی برای نگرانی نیست، اما آگاهی از آن میتواند به حفظ سلامت کلی کمک کند.
درمان بالا بودن SGPT و راهکارهای پیشگیری
افزایش سطح SGPT در آزمایش خون میتواند زنگ خطری برای سلامت کبد باشد، اما خوشبختانه با اقدامات مناسب، بسیاری از موارد قابل مدیریت یا حتی معکوس هستند. اگر بهدنبال راهحل برای سؤال “SGPT در آزمایش خون چیست؟” و نحوه برخورد با نتایج غیرطبیعی آن هستید، این بخش راهنماییهای کاربردی بر اساس تجربیات پزشکی و منابع معتبر را ارائه میدهد.
درمان بالا بودن SGPT
درمان اصلی به شناسایی و رفع علت افزایش SGPT بستگی دارد. اگر دلیل آن مصرف الکل باشد، قطع کامل یا کاهش آن میتواند بهتدریج سطح این آنزیم را به “میزان نرمال SGPT” بازگرداند. در مواردی مثل هپاتیت ویروسی، داروهای ضدویروسی (مانند برای هپاتیت B یا C) تحت نظر پزشک تجویز میشوند. برای کبد چرب غیرالکلی، که در ایران به دلیل رژیمهای پرچرب شایع است، کاهش وزن و کنترل دیابت میتواند مؤثر باشد. اگر داروهایی مثل استاتینها یا NSAIDها عامل باشند، پزشک ممکن است دوز را تنظیم یا داروی جایگزین پیشنهاد کند. در شرایط حاد مثل سیروز، درمان تخصصیتر و گاهی پیوند کبد لازم است.
راهکارهای پیشگیری
پیشگیری از بالا رفتن SGPT با تغییر سبک زندگی امکانپذیر است. رژیم غذایی مدیترانهای، که سرشار از میوهها، سبزیجات، ماهی و روغن زیتون است، به سلامت کبد کمک میکند. ورزش منظم (حداقل ۱۵۰ دقیقه در هفته) و حفظ وزن ایدهآل میتواند از تجمع چربی در کبد جلوگیری کند. اجتناب از الکل و مشورت با پزشک قبل از مصرف داروهای طولانیمدت نیز توصیه میشود. چکاپهای دورهای، بهویژه اگر سابقه خانوادگی بیماری کبدی دارید، میتواند زودهنگام مشکلات را شناسایی کند.
نظارت و پیگیری
در آزمایشگاه پاتوبیولوژی ثمره، با انجام آزمایشهای منظم و ارائه نتایج دقیق، بیماران میتوانند روند بهبودی خود را زیر نظر داشته باشند. تکرار آزمایش SGPT پس از تغییر سبک زندگی یا درمان، به ارزیابی اثربخشی کمک میکند. اگر سطح این آنزیم همچنان بالا باشد، متخصصان ما با همکاری پزشک شما، برنامهای جامع برای پیگیری ارائه خواهند داد. با اقدامات بهموقع، میتوانید سلامت کبد خود را حفظ کرده و از عوارض جدی جلوگیری کنید.
عوامل تاثیرگذار بر نتایج آزمایش SGPT
نتایج آزمایش SGPT میتواند تحت تأثیر عوامل مختلفی قرار گیرد که دانستن آنها برای تفسیر دقیقتر، بهویژه برای افرادی که بهدنبال پاسخ “SGPT در آزمایش خون چیست؟” هستند، ضروری است. آگاهی از این عوامل به شما کمک میکند تا شرایطی که ممکن است بر “میزان نرمال SGPT” تأثیر بگذارد را بهتر درک کنید و نتایج را با دقت بیشتری ارزیابی کنید. ?
تأثیر داروها
مصرف برخی داروها میتواند سطح SGPT را تغییر دهد. بهعنوان مثال، استاتینها (برای کاهش کلسترول)، آنتیبیوتیکها، و داروهای ضدالتهابی غیراستروئیدی (NSAIDها) ممکن است بهطور موقت این آنزیم را افزایش دهند. اگر دارویی بهصورت طولانیمدت استفاده میکنید، مشورت با پزشک برای تنظیم دوز یا توقف موقت قبل از آزمایش توصیه میشود. ✅
مصرف الکل
مصرف الکل، حتی در مقادیر کم، میتواند به کبد فشار وارد کند و سطح SGPT را بالا ببرد. افرادی که بهتازگی الکل مصرف کردهاند، بهتر است حداقل ۲۴ تا ۴۸ ساعت قبل از آزمایش از آن اجتناب کنند تا نتایج دقیقتری به دست آید. ?
فعالیت بدنی و ورزش
ورزش شدید یا فعالیت بدنی سنگین، بهویژه اگر غیرمعمول باشد، میتواند بهطور موقت سطح SGPT را افزایش دهد، زیرا این آنزیم در عضلات نیز وجود دارد. برای بهدست آوردن “میزان نرمال SGPT”، بهتر است قبل از آزمایش از فعالیتهای سنگین خودداری کنید. ?️♂️
شرایط خاص
بارداری، استرس شدید، یا بیماریهای حاد میتوانند بر نتایج تأثیر بگذارند. در زنان باردار، تغییرات هورمونی ممکن است سطح SGPT را کمی تغییر دهد که معمولاً طبیعی است. همچنین، در زمان بیماری، بدن ممکن است پاسخهای متفاوتی نشان دهد. ?
سلامت کبد یکی از مهم
جهت مشاوره و هماهنگی میتوانید به سایت
مراجعه نمایید و یا با شماره تلفن های درج شده تماس حاصل فرمایید.
شماره واتساپ 09129001037
SGPT در آزمایش خون چیست؟
SGPT در آزمایش خون چیست؟ SGPT یا آلانین آمینوترانسفراز (ALT) یک آنزیم است که عمدتاً در کبد یافت میشود و برای متابولیسم پروتئینها ضروری است. افزایش آن در خون معمولاً نشاندهنده آسیب کبدی است.
میزان نرمال SGPT در زنان چقدر است؟
میزان نرمال SGPT در زنان چقدر است؟ رنج نرمال برای زنان معمولاً بین ۷ تا ۳۵ واحد در لیتر (U/L) است، اما این مقدار ممکن است با توجه به شرایط بدنی و سن کمی متفاوت باشد.
علل بالا بودن SGPT چیست؟
علل بالا بودن SGPT چیست؟ دلایل متعددی از جمله هپاتیت ویروسی، کبد چرب، مصرف الکل، یا عوارض دارویی میتواند باعث افزایش سطح SGPT شود. شدت افزایش به نوع مشکل بستگی دارد.
SGPT بالا خطرناک است؟
SGPT بالا خطرناک است؟ بستگی به میزان و علت آن دارد. افزایش خفیف ممکن است موقتی باشد، اما مقادیر بالای مداوم (بیش از ۳۰۰ U/L) نیاز به بررسی فوری پزشکی دارد.
آیا برای آزمایش SGPT نیاز به ناشتا بودن است؟
آیا برای آزمایش SGPT نیاز به ناشتا بودن است؟ بهتنهایی خیر، اما اگر بخشی از پانل کبدی باشد، ناشتا بودن ۸ تا ۱۲ ساعت توصیه میشود. بهتر است با پزشک مشورت کنید.
چگونه میتوان سطح SGPT را کاهش داد؟
چگونه میتوان سطح SGPT را کاهش داد؟ با شناسایی علت (مثل قطع الکل یا تنظیم دارو)، رژیم غذایی سالم، ورزش، و گاهی درمان دارویی تحت نظر پزشک میتوان آن را مدیریت کرد.
آیا پایین بودن SGPT مشکلساز است؟
آیا پایین بودن SGPT مشکلساز است؟ معمولاً خیر، اما در موارد نادر ممکن است به کمبود ویتامین B6 یا تغییرات هورمونی مرتبط باشد که نیاز به بررسی دارد.
نتیجهگیری
آگاهی از اهمیت آزمایش SGPT و تفسیر صحیح نتایج آن میتواند گامی مهم در حفظ سلامت کبد و پیشگیری از عوارض احتمالی باشد. این مقاله تلاش کرد تا با پاسخ به سؤال “SGPT در آزمایش خون چیست؟” و پوشش جنبههای مختلف از تعریف این آنزیم تا میزان نرمال، علل تغییرات، و راهکارهای مدیریت آن، اطلاعات جامعی در اختیارتان قرار دهد. میزان نرمال SGPT، که معمولاً بین ۷ تا ۵۶ واحد در لیتر برای بزرگسالان است، بسته به جنسیت و شرایط بدنی میتواند متفاوت باشد و افزایش یا کاهش آن میتواند نشانههایی از وضعیت کبد ارائه دهد.
عواملی مانند مصرف الکل، داروها، و سبک زندگی در تغییر سطح این آنزیم نقش دارند، اما با تشخیص بهموقع و اقدامات مناسب مثل رژیم غذایی سالم و چکاپهای دورهای، میتوان از مشکلات جدی پیشگیری کرد. تجربه نشان داده که توجه به علائم اولیه و مشورت با متخصص پس از دریافت نتایج، میتواند تفاوت بزرگی ایجاد کند. اگر نتیجه آزمایش شما خارج از رنج طبیعی باشد، انجام آزمایشهای تکمیلی و همکاری با یک مرکز معتبر میتواند راهنمای مطمئنی برای تصمیمگیری باشد.
در نهایت، سلامت کبد شما سرمایهای ارزشمند است که با مراقبت و آگاهی حفظ میشود. با در نظر گرفتن نکات ذکرشده و مراجعه به مراکز مجهز برای تحلیل دقیق، میتوانید از وضعیت خود مطمئن شوید. این اطلاعات بر اساس دادههای علمی و تجربیات عملی گردآوری شده تا به شما در مسیر سلامتی کمک کند.





دیدگاهتان را بنویسید